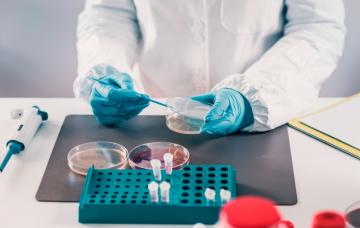
Diagnóstico de la fiebre del valle del Rift

- 1

Qué es la fiebre del valle del Rift
La fiebre del valle del Rift es una infección transmitida por los mosquitos al ganado, que puede afectar también a las personas de forma leve, o grave.
Leer más - 2

Causas de la fiebre del valle del Rift: cómo se contagia
El contagio de la fiebre del valle del Rift a los seres humanos se suele producir por contacto con la sangre o los tejidos de los animales infectados.
Leer más - 3

Síntomas de la fiebre del valle del Rift
Los síntomas de la fiebre del valle del Rift pueden ser similares a los de la gripe, o más graves si existe afectación ocular, encefalitis, o hemorragias.
Leer más - 4

Diagnóstico de la fiebre del valle del Rift
Para el diagnóstico de la fiebre del valle del Rift se puede hacer un análisis de sangre o un examen de fondo de ojo, pero también hay pruebas específicas.
Leer más - 5

Tratamiento y prevención de la fiebre del valle del Rift
El tratamiento de la fiebre del valle del Rift es de soporte, y para prevenirla hay que extremar la higiene en el contacto con los animales infectados.
Leer más
También te puede interesar...
Lo más leído esta semana
- 1
Efectos del cannabis medicinal en los pacientes con diabetes: ¿qué se sabe?
- 2
Padres quemados: impacto emocional de educar a un adolescente
- 3
¿Los niños realmente necesitan suplementos vitamínicos?
- 4
Caries, ¿avanza o se detiene? Cómo evitar que despierten las lesiones inactivas
- 5
Por qué es un temor infundado volver a coger peso tras un cáncer de mama
- 6
¿Podemos prevenir el TDAH? Intervenciones antes de los cinco años
- 7
¿Podemos enseñar a los niños a pisar el freno? Qué es la inhibición conductual
- 8
Balanitis, cómo evitar la inflamación del glande
- 9
Petting, redescubre el placer del sexo sin penetración
- 10
Test ¿Eres celoso? Descubre si los celos te dominan